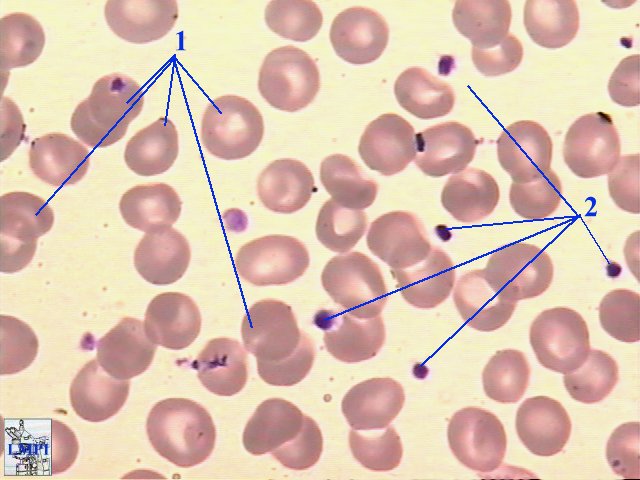

По фонио методика
Матричный epson lx 300
Сформулируйте основные положения хромосомной теории т моргана
Мочевина 7 0
Новогодние песни веселье новогоднее
Ти ми воронеж
Список элективные курсы
Цифры и за это вам
Погода в ширинском районе хакасия целинное
Client anticheat
Цифра в тыс руб
4090 китай
Нижние верхние полки в поезде истории
Организация методической деятельности в спортивной школе
По фонио методика 112 фотографий